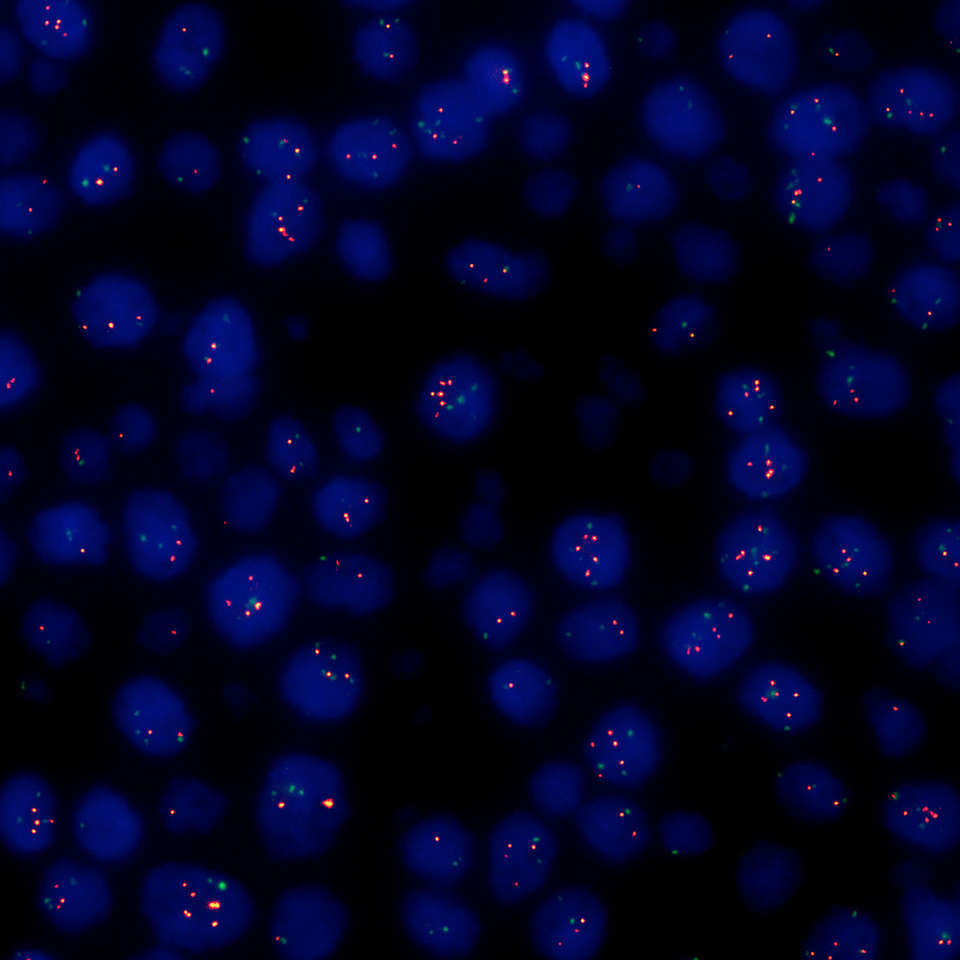
undefined undefined

Digital Sight 10
产品简述:Digital Sight 10实现了6K高画质,单台相机同时支持彩色与单色成像。这款高性能相机还具备高帧率,可以快速预览高清图像。
025-83194005
电话咨询

产品简述:Digital Sight 10实现了6K高画质,单台相机同时支持彩色与单色成像。这款高性能相机还具备高帧率,可以快速预览高清图像。
025-83194005
电话咨询
主要特性
大视野观察

胃,SMA染色,17×12拼接图像(物镜:CFI Plan Apochromat 40XC)
全画幅CMOS传感器,支持实时大视野成像。
之前在倒置显微镜上才能实现的25mm大视野(FOV),现在正置显微镜也能支持了,这使得单次成像覆盖的样品区域更大。大视野成像使图像拼接更加高效,大大节省了拍摄时间。
*正置显微镜仅限Ni系列(明场/三目观察筒)支持
高清观察


Digital Sight 10 传统机型(DS-Ri2)
肾组织(WGA:488)(物镜:CFI Plan Apochromat VC 20X)
以前所未有的6K超清晰画质轻松捕捉样品精细结构
可捕捉高达6000×3984像素(2390万像素)的显微图像,非常适合精细结构的观察与定位分析。
快速实时图像显示
高帧率下对运动样品进行完美实时成像
Digital Sight 10能以9帧/秒实时显示6000×3984像素(2390万像素)的图像,或以66帧/秒实时显示1920×1080像素(210万像素)的图像。在高帧率下可以轻松实现高清图像的实时精细聚焦。通过使用ROI模式,可以在更高的速度下拍摄任何指定位置。
高灵敏度与低噪声
乳腺癌,FISH 方法(物镜:CFI Plan Apochromat Lambda D100X Oil)
适合有大视野和高清晰需求的荧光观察
Digital Sight 10可实现等同于ISO200彩色模式以及ISO800单色模式的高灵敏度。在单色和彩色图像采集中都能以高信噪比进行清晰的荧光观察。
更广泛的应用场景
单台相机即可实现彩色拍摄与单色拍摄(手动操作)


彩色模式 单色模式
当插入彩色滤光片后,可拍摄400-680nm彩色图像 当拆下彩色滤光片后,可拍摄400-850nm单色图像
*更换为单色红外滤光片
电动切换功能(电动操作(使用1x电子适配器))
手动或电动方式轻松切换色彩模式
Digital Sight 10可通过运用专门的成像软件进行电动切换,或将滤光片从显微镜相机底部插槽安装/拆卸以进行手动切换,从而轻松切换色彩模式。

1x电子适配器

在成像软件中仅需一个动作即可切换
电动操作时需要一个1x电子适配器和一台配备专业成像软件NIS-Elements的电脑。
以单个传感器实现稳定拍摄
单个传感器即可捕捉彩色和单色图像,即使在切换色彩模式后也可以保持图像一致而不发生位移。操作简便无需使用多台相机。

明场(单色)

明场(彩色)

荧光(单色)

荧光(单色)
斑马鱼(物镜:SHR Plan Apo 1X)
可获取近红外图像的单色模式:对生物样品低损伤的荧光观察
Digital Sight 10单色模式支持近红外(700nm)荧光图像的捕捉,这是传统彩色相机难以实现的。由于荧光灵敏度延伸至近红外区域,此相机也适用于厚样品与光毒性不耐受样品的荧光图像采集。


正置显微镜 ECLIPSE Ni 肾癌,波形纤维蛋白染色(物镜:CFI Plan Apochromat Lambda D 20X)
生物显微镜用物镜 Lambda D
精细结构观察应用
对图像进行局部放大之后仍然很清晰,即便在图像边缘也基本没有模糊或色彩渗出的现象,ECLIPSE Ni支持以高分辨率和高色彩保真度对样品进行日常观察与检查。

倒置显微镜系统 ECLIPSE Ti2
生物显微镜用物镜 Lambda D
三维成像应用
ECLIPSE Ti2利用大视野优势(视场数25),在拍摄三维或其他多维大数据时实现高通量。再结合图像处理功能,即便在样品深部也能以更高的信噪比捕捉清晰的图像。


研究级体视显微镜SMZ25/18 斑马鱼幼虫(明场/心肌层 GFP)(物镜:SHR Plan Apo 2X )
模式生物成像应用
SMZ25/18体视显微镜以高帧率提供高清晰度图像。拍摄完美、明亮的图像而不会错过高速的生物反应过程。低噪声使此系统成为时间序列成像的理想选择。
*本公司产品中任何描述性词语不具备对其他品牌产品的排他性,仅限于对比本品牌前期产品。
如有疑异,可通过025-83194005联系。*
| Digital Sight 10 | |
|---|---|
| 图像传感器 | 尼康FX格式 彩色CMOS图像传感器 尺寸:35.8×23.8毫米 |
| 可刻录像素 | 6000×3984像素 |
| 镜头卡口 | F卡口 |
| ISO感光度 | 相当于ISO200(彩色模式) 相当于ISO800(单色模式) (彩色模式下ISO125至8000可选/ 单色模式下ISO500至32000可选) |
| 实时显示模式* | 全像素(6000×3984):9fps 全高清 3×3像素平均值 (1920×1080):66fps |
| 曝光时间 | 100微秒~120秒 |
| 光度测定模式 | 平均光度测量:测光区域内的平均强度 峰值光度测量:测光区域内的最大强度 |
| 曝光控制 | 一次性自动曝光:曝光时间会在相机的最佳范围内自动调整一次 连续自动曝光:连续执行自动曝光调节以保持相机内的曝光 手动曝光:曝光时间和增益设置是手动完成的 |
| 曝光校正 | 平均计量:±1EV步长:1/6EV (根据色调有一些限制条件) 峰值保持测量:-1EV至±0EV |
| 接口 | USB3.2GEN1,2(连接PC)×1 外部触发×1 |
| 电源 | AC100-240V 50Hz/60Hz |
| 能量消耗 | 18W |
| 外形尺寸 | 113(宽)×108(深)×110(高)mm |
| 重量 | 1100克(约) |
| 操作环境 | 0-40℃,最大60%RH(无冷凝) |
*最大帧速率取决于曝光时间。
尼康FX格式CMOS图像传感器能够实现高清晰度实时采集图像。
Digital Sight 10实现了6K高画质,单台相机同时支持彩色与单色成像。
这款高性能相机还具备高帧率,可以快速预览高清图像。
